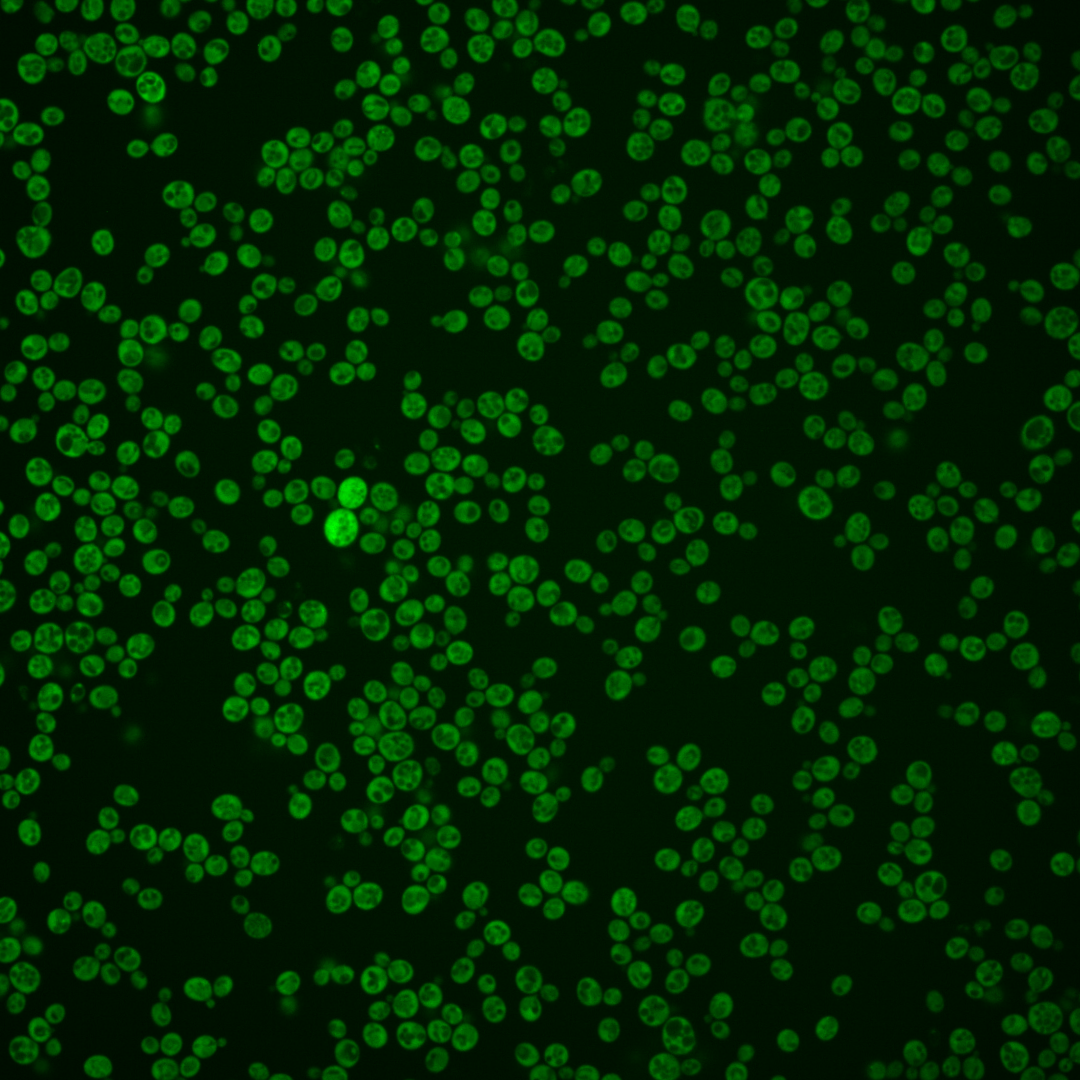
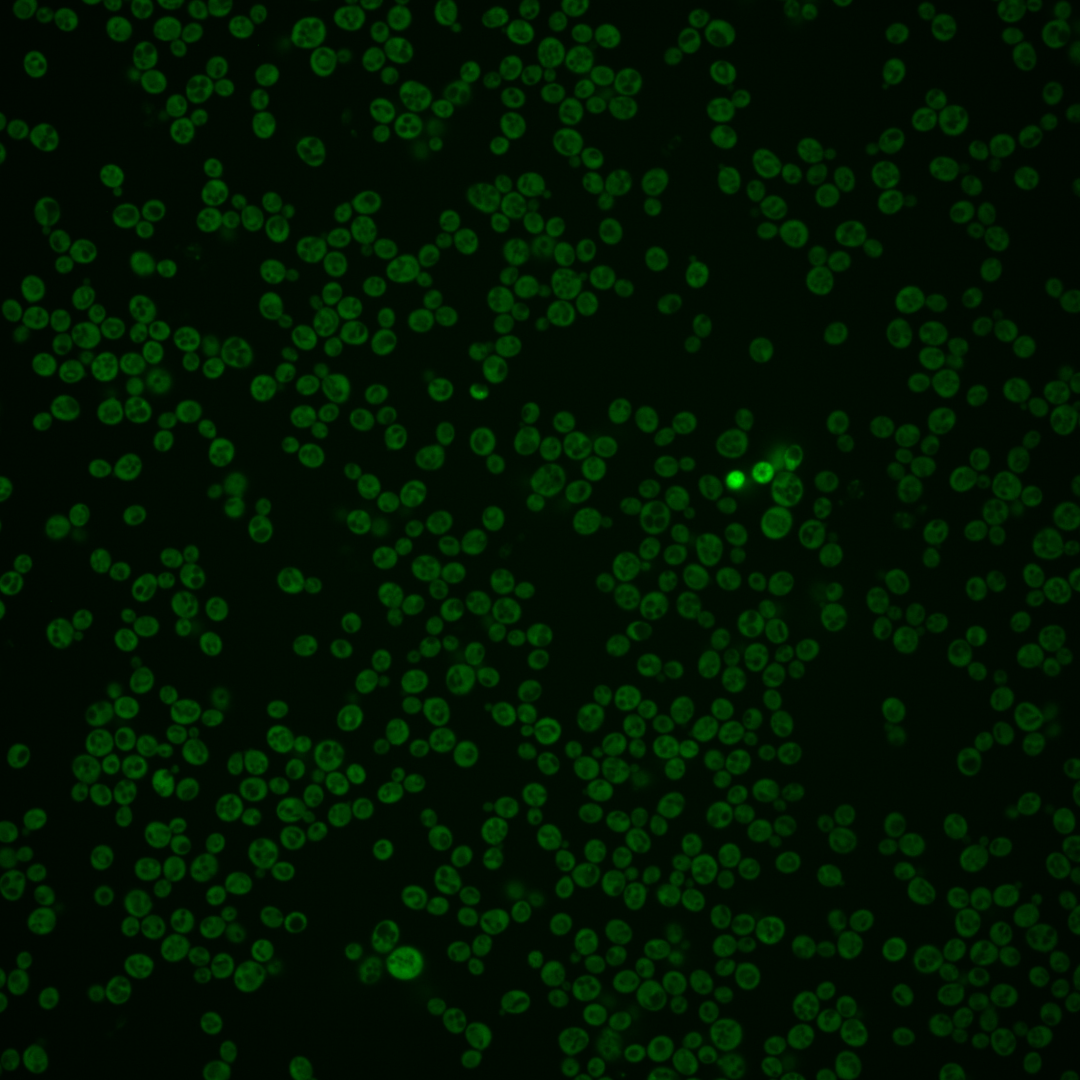
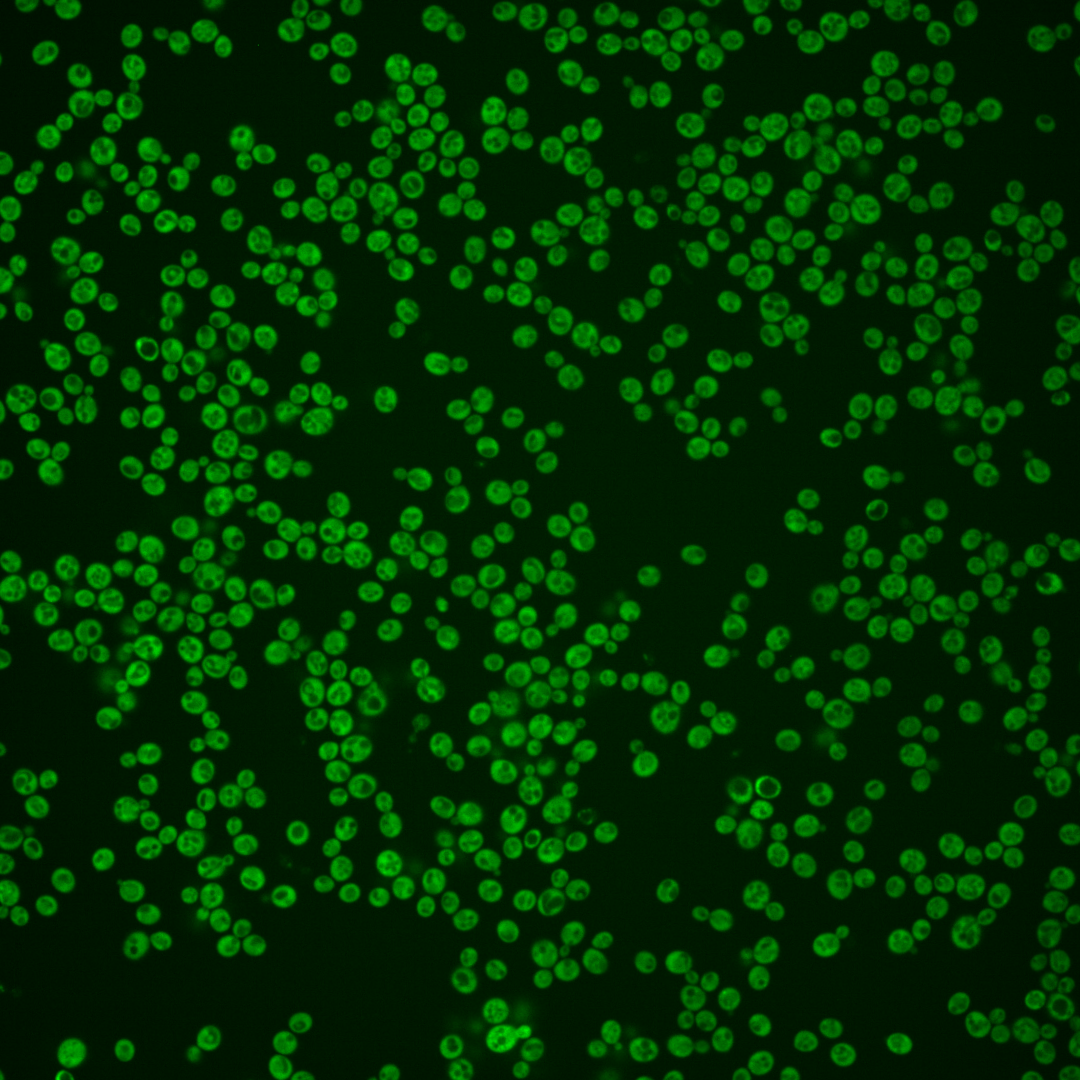
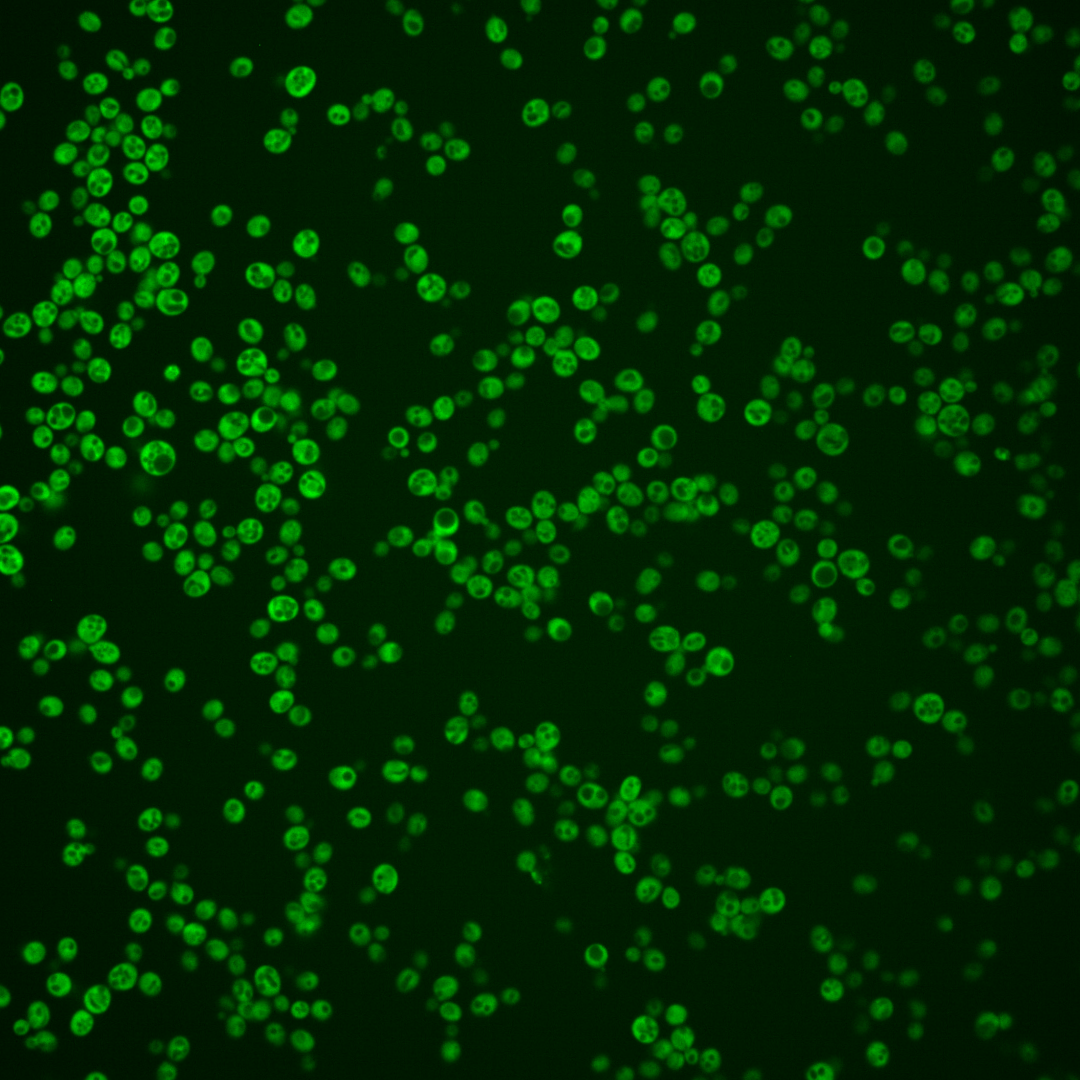
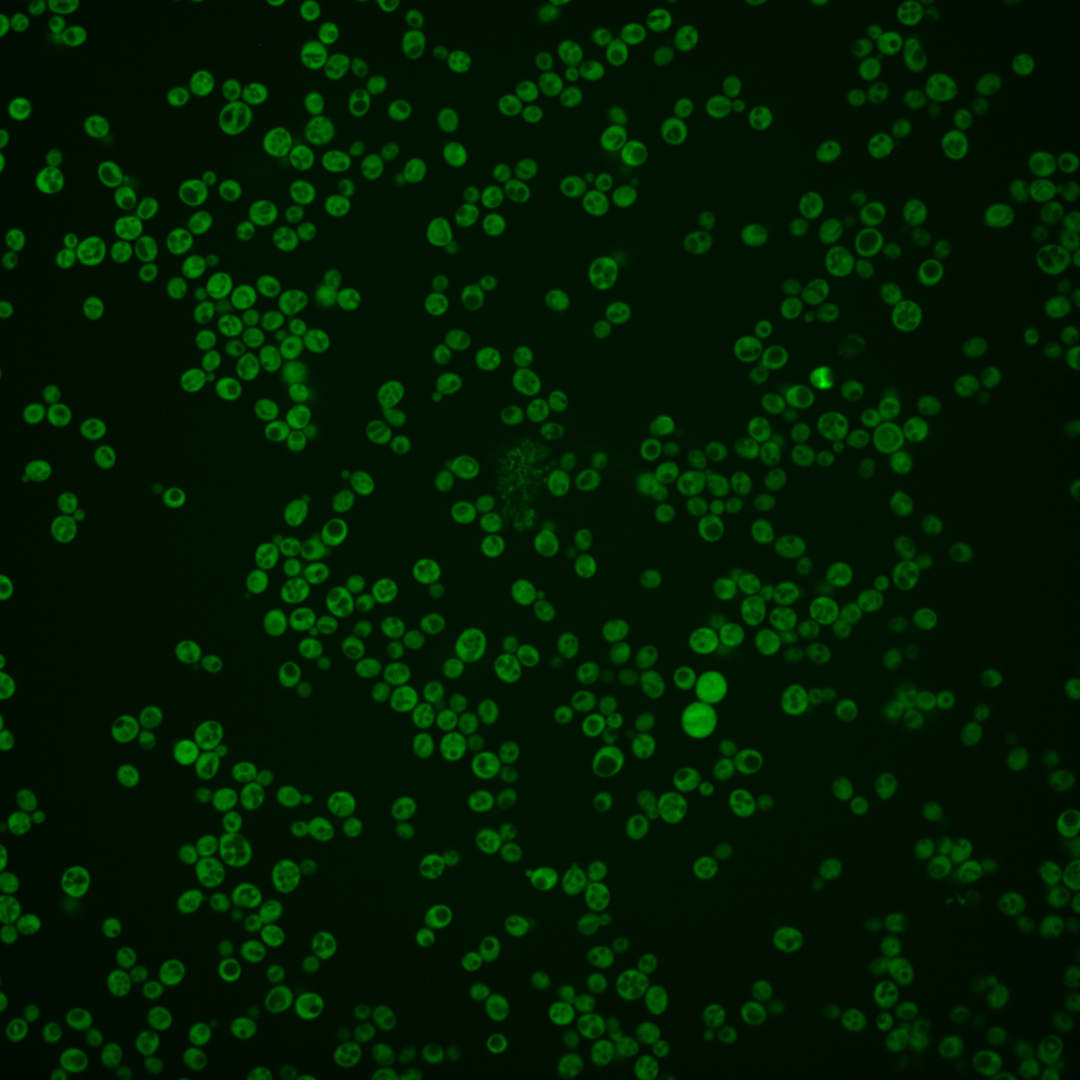
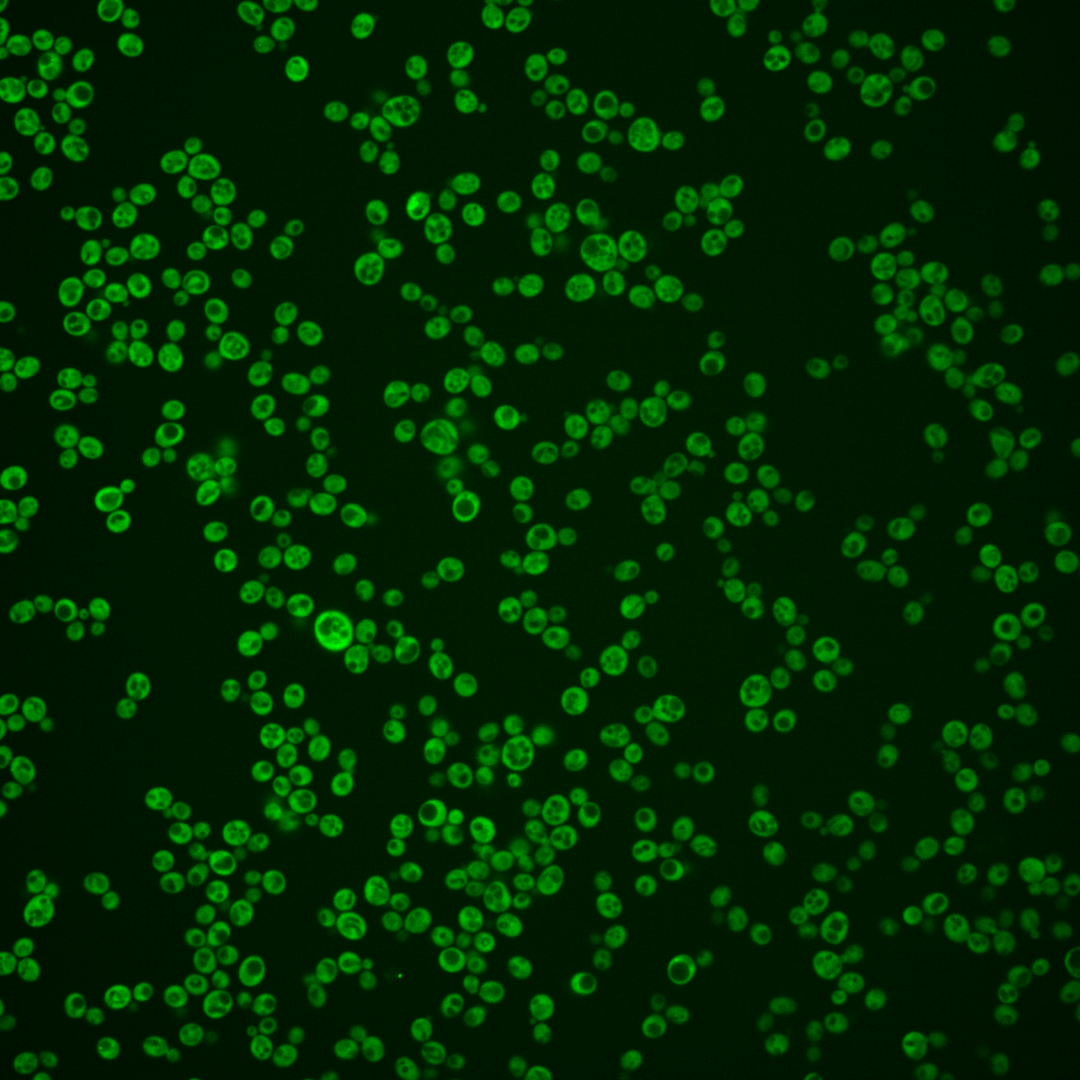
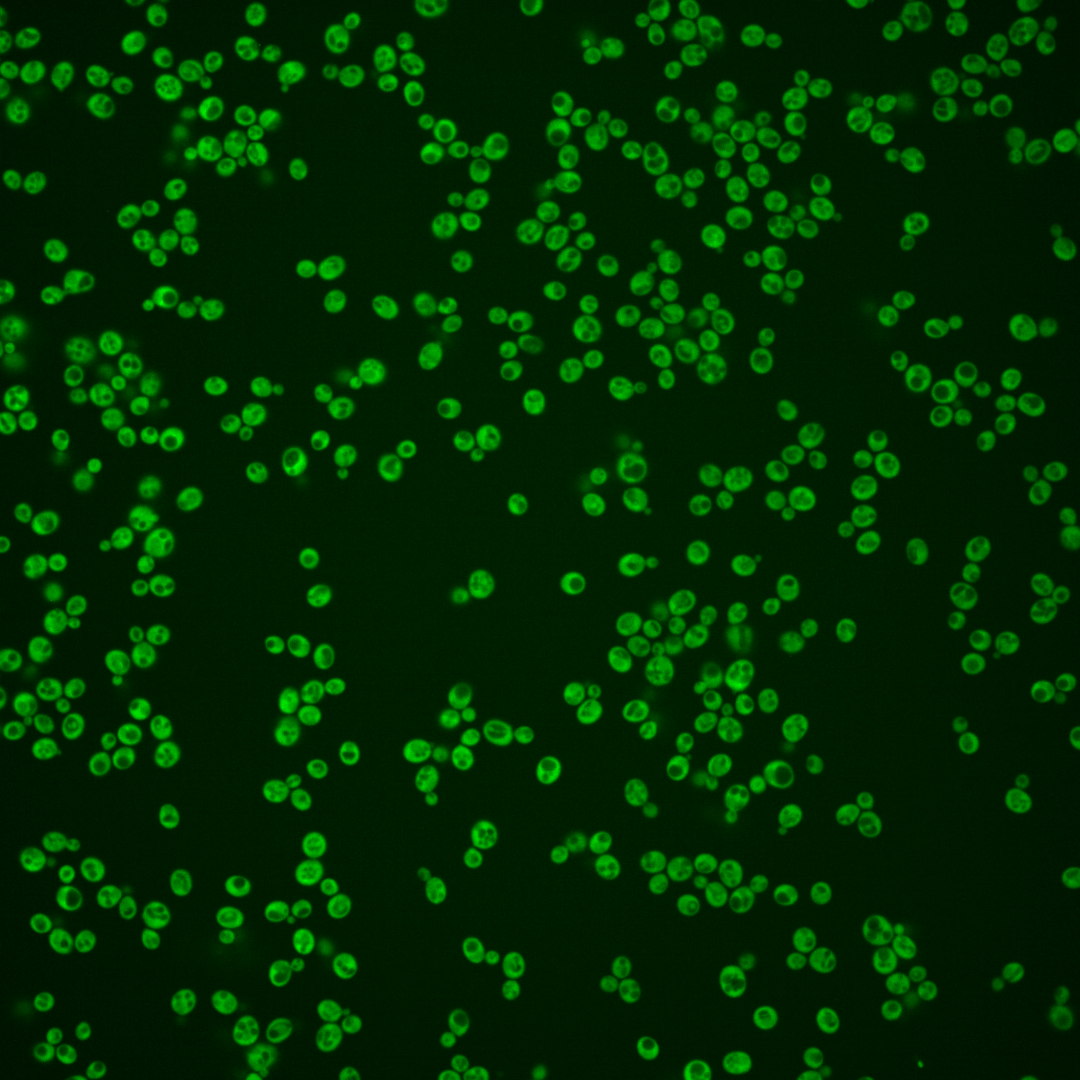

| Standard name | |
|---|---|
| Human Ortholog | |
| Description | Member of the conserved GPN-loop GTPase family; has a role in transport of RNA polymerase II to the nucleus; exhibits GTP-dependent binding to PolII; has ATPase activity; involved in sister chromatid cohesion; phosphorylated by the Pcl1p-Pho85p kinase complex; human homolog XAB1 interacts with human RNA polymerase II; protein abundance increases in response to DNA replication stress |
Micrographs




















































































Sub-cellular Localization
Yeast GFP Assignment
Protein Abundance
Localization Change
External localization resources
| ensLOC | DeepLoc | |||||||||||||||||||||||
|---|---|---|---|---|---|---|---|---|---|---|---|---|---|---|---|---|---|---|---|---|---|---|---|---|
| Localization | WT1 | WT2 | WT3 | RAP60 | RAP140 | RAP220 | RAP300 | RAP380 | RAP460 | RAP540 | RAP620 | RAP700 | HU80 | HU120 | HU160 | rpd3Δ_1 | rpd3Δ_2 | rpd3Δ_3 | WT1 | WT2 | WT3 | AF100 | AF140 | AF180 |
| Cortical Patches | 0 | 1 | 0 | 2 | 1 | 6 | 14 | 6 | 7 | 5 | 1 | 3 | 0 | 0 | 0 | 0 | 0 | 0 | 0 | 0 | 3 | 0 | 0 | 0 |
| Bud | 2 | 0 | 0 | 2 | 0 | 3 | 10 | 3 | 6 | 14 | 11 | 17 | 1 | 1 | 0 | 0 | 0 | 0 | 1 | 0 | 0 | 0 | 0 | 0 |
| Bud Neck | 0 | 0 | 0 | 0 | 0 | 0 | 0 | 0 | 0 | 0 | 0 | 0 | 0 | 0 | 0 | 0 | 0 | 0 | 0 | 0 | 1 | 0 | 0 | 0 |
| Bud Site | 0 | 0 | 0 | 0 | 0 | 0 | 0 | 0 | 0 | 0 | 0 | 0 | 0 | 0 | 0 | 0 | 0 | 0 | – | – | – | – | – | – |
| Cell Periphery | 0 | 0 | 12 | 3 | 18 | 8 | 36 | 36 | 23 | 37 | 27 | 26 | 14 | 21 | 17 | 3 | 10 | 5 | 0 | 0 | 1 | 0 | 0 | 0 |
| Cytoplasm | 134 | 177 | 270 | 277 | 406 | 375 | 419 | 360 | 273 | 337 | 233 | 273 | 475 | 612 | 562 | 156 | 244 | 181 | 127 | 170 | 263 | 301 | 300 | 425 |
| Endoplasmic Reticulum | 0 | 4 | 19 | 4 | 10 | 13 | 45 | 39 | 22 | 24 | 13 | 11 | 11 | 13 | 8 | 3 | 5 | 3 | 1 | 2 | 13 | 1 | 2 | 10 |
| Endosome | 0 | 0 | 0 | 0 | 1 | 2 | 1 | 0 | 0 | 5 | 1 | 2 | 1 | 0 | 0 | 0 | 0 | 0 | 0 | 0 | 0 | 1 | 0 | 2 |
| Golgi | 1 | 0 | 1 | 1 | 1 | 1 | 0 | 0 | 0 | 0 | 0 | 0 | 0 | 0 | 0 | 0 | 0 | 1 | 1 | 0 | 2 | 0 | 0 | 0 |
| Mitochondria | 2 | 0 | 3 | 14 | 40 | 77 | 219 | 150 | 121 | 238 | 174 | 198 | 0 | 0 | 0 | 0 | 4 | 3 | 0 | 0 | 3 | 0 | 1 | 0 |
| Nucleus | 0 | 1 | 0 | 0 | 2 | 1 | 1 | 2 | 0 | 0 | 0 | 1 | 0 | 1 | 0 | 2 | 2 | 1 | 0 | 2 | 0 | 1 | 0 | 4 |
| Nuclear Periphery | 0 | 0 | 0 | 0 | 0 | 0 | 1 | 2 | 0 | 0 | 1 | 2 | 0 | 0 | 0 | 0 | 0 | 0 | 0 | 0 | 0 | 0 | 0 | 2 |
| Nucleolus | 0 | 0 | 0 | 0 | 0 | 0 | 0 | 1 | 0 | 1 | 0 | 0 | 0 | 0 | 0 | 0 | 0 | 1 | 0 | 0 | 0 | 0 | 0 | 1 |
| Peroxisomes | 0 | 0 | 0 | 0 | 0 | 0 | 0 | 0 | 0 | 0 | 0 | 0 | 0 | 0 | 0 | 0 | 0 | 0 | 0 | 0 | 0 | 0 | 0 | 0 |
| SpindlePole | 0 | 0 | 0 | 0 | 0 | 0 | 1 | 0 | 0 | 0 | 0 | 0 | 0 | 0 | 0 | 0 | 0 | 0 | 0 | 0 | 0 | 0 | 0 | 0 |
| Vac/Vac Membrane | 0 | 1 | 2 | 2 | 9 | 10 | 23 | 36 | 22 | 24 | 18 | 30 | 1 | 0 | 3 | 4 | 7 | 17 | 0 | 2 | 0 | 5 | 4 | 4 |
| Unique Cell Count | 135 | 184 | 292 | 291 | 445 | 440 | 633 | 547 | 402 | 548 | 402 | 456 | 483 | 621 | 571 | 162 | 255 | 202 | 134 | 179 | 294 | 314 | 315 | 460 |
| Labelled Cell Count | 139 | 184 | 307 | 305 | 488 | 496 | 770 | 635 | 474 | 685 | 479 | 563 | 503 | 648 | 590 | 168 | 272 | 212 | 134 | 179 | 294 | 314 | 315 | 460 |
Yeast GFP Assignment
Protein Abundance
| Screen | WT1 | WT2 | WT3 | RAP60 | RAP140 | RAP220 | RAP300 | RAP380 | RAP460 | RAP540 | RAP620 | RAP700 | HU80 | HU120 | HU160 | rpd3Δ_1 | rpd3Δ_2 | rpd3Δ_3 | AF100 | AF140 | AF180 |
|---|---|---|---|---|---|---|---|---|---|---|---|---|---|---|---|---|---|---|---|---|---|
| Mean Cell GFP Intensity (1e-4) | 12.3 | 16.1 | 13.3 | 12.1 | 10.9 | 9.4 | 8.6 | 8.5 | 8.0 | 7.6 | 7.2 | 7.1 | 15.3 | 14.9 | 14.3 | 22.0 | 24.5 | 23.3 | 15.8 | 15.7 | 16.3 |
| Std Deviation (1e-4) | 2.1 | 2.9 | 2.1 | 1.7 | 1.5 | 1.6 | 1.6 | 1.7 | 1.6 | 1.7 | 1.4 | 1.5 | 2.8 | 2.7 | 2.6 | 7.8 | 8.1 | 7.8 | 2.6 | 2.9 | 3.2 |
| Intensity Change (Log2) | – | – | – | -0.14 | -0.29 | -0.51 | -0.63 | -0.64 | -0.73 | -0.81 | -0.9 | -0.91 | 0.2 | 0.16 | 0.1 | 0.73 | 0.88 | 0.81 | 0.24 | 0.24 | 0.29 |
Localization Change
| Localization | RAP60 | RAP140 | RAP220 | RAP300 | RAP380 | RAP460 | RAP540 | RAP620 | RAP700 | HU80 | HU120 | HU160 | rpd3Δ_1 | rpd3Δ_2 | rpd3Δ_3 |
|---|---|---|---|---|---|---|---|---|---|---|---|---|---|---|---|
| Cortical Patches | 0 | 0 | 0 | 0 | 0 | 0 | 0 | 0 | 0 | 0 | 0 | 0 | 0 | 0 | 0 |
| Bud | 0 | 0 | 0 | 0 | 0 | 0 | 0 | 0 | 3.3 | 0 | 0 | 0 | 0 | 0 | 0 |
| Bud Neck | 0 | 0 | 0 | 0 | 0 | 0 | 0 | 0 | 0 | 0 | 0 | 0 | 0 | 0 | 0 |
| Bud Site | 0 | 0 | 0 | 0 | 0 | 0 | 0 | 0 | 0 | 0 | 0 | 0 | 0 | 0 | 0 |
| Cell Periphery | -2.3 | 0 | -1.9 | 1.0 | 1.5 | 1.0 | 1.6 | 1.5 | 1.0 | -0.9 | -0.5 | -0.9 | -1.3 | -0.1 | -1.0 |
| Cytoplasm | 1.4 | -0.6 | -3.0 | -8.5 | -8.5 | -7.7 | -9.5 | -10.0 | -9.8 | 4.1 | 4.7 | 4.5 | 1.6 | 1.6 | -1.1 |
| Endoplasmic Reticulum | -3.2 | -2.9 | -2.3 | 0.3 | 0.3 | -0.6 | -1.3 | -2.0 | -2.8 | -3.0 | -3.4 | -4.1 | -2.2 | -2.6 | -2.7 |
| Endosome | 0 | 0 | 0 | 0 | 0 | 0 | 0 | 0 | 0 | 0 | 0 | 0 | 0 | 0 | 0 |
| Golgi | 0 | 0 | 0 | 0 | 0 | 0 | 0 | 0 | 0 | 0 | 0 | 0 | 0 | 0 | 0 |
| Mitochondria | 2.7 | 4.5 | 7.0 | 11.1 | 9.4 | 9.9 | 12.9 | 12.6 | 12.8 | 0 | 0 | 0 | 0 | 0 | 0 |
| Nucleus | 0 | 0 | 0 | 0 | 0 | 0 | 0 | 0 | 0 | 0 | 0 | 0 | 0 | 0 | 0 |
| Nuclear Periphery | 0 | 0 | 0 | 0 | 0 | 0 | 0 | 0 | 0 | 0 | 0 | 0 | 0 | 0 | 0 |
| Nucleolus | 0 | 0 | 0 | 0 | 0 | 0 | 0 | 0 | 0 | 0 | 0 | 0 | 0 | 0 | 0 |
| Peroxisomes | 0 | 0 | 0 | 0 | 0 | 0 | 0 | 0 | 0 | 0 | 0 | 0 | 0 | 0 | 0 |
| SpindlePole | 0 | 0 | 0 | 0 | 0 | 0 | 0 | 0 | 0 | 0 | 0 | 0 | 0 | 0 | 0 |
| Vacuole | 0 | 0 | 0 | 2.6 | 3.9 | 3.4 | 2.9 | 2.9 | 3.9 | 0 | 0 | 0 | 0 | 0 | 4.4 |
External localization resources
Images






























Protein Concentration and Protein Localization Data
| R1 | R2 | R3 | ||||||||||||||||
|---|---|---|---|---|---|---|---|---|---|---|---|---|---|---|---|---|---|---|
| G1 Pre-START | G1 Post-START | S/G2 | Metaphase | Anaphase | Telophase | G1 Pre-START | G1 Post-START | S/G2 | Metaphase | Anaphase | Telophase | G1 Pre-START | G1 Post-START | S/G2 | Metaphase | Anaphase | Telophase | |
| Concentration | 10.7598 | 14.1615 | 12.6967 | 12.322 | 10.8947 | 12.7188 | 9.1941 | 13.3073 | 12.2707 | 10.6878 | 11.3606 | 12.2369 | 6.8945 | 11.7274 | 9.8708 | 8.8211 | 9.9018 | 10.8437 |
| Actin | 0.021 | 0.0002 | 0.0029 | 0.0007 | 0.0378 | 0.0024 | 0.0188 | 0.0004 | 0.0042 | 0.0189 | 0.0011 | 0.0007 | 0.0296 | 0.0011 | 0.0071 | 0.0225 | 0.0004 | 0.0002 |
| Bud | 0.0052 | 0.0002 | 0.006 | 0.0004 | 0.0005 | 0.0005 | 0.0008 | 0.0002 | 0.0002 | 0.0014 | 0.0002 | 0.0002 | 0.0019 | 0.0002 | 0.0004 | 0.0012 | 0.0004 | 0.0002 |
| Bud Neck | 0.0012 | 0.0002 | 0.0007 | 0.0007 | 0.0007 | 0.0013 | 0.0037 | 0.0002 | 0.0004 | 0.0013 | 0.0004 | 0.001 | 0.0028 | 0.0001 | 0.0005 | 0.0006 | 0.0005 | 0.0009 |
| Bud Periphery | 0.0022 | 0.0001 | 0.0025 | 0.0001 | 0.0003 | 0.0003 | 0.0008 | 0.0001 | 0.0001 | 0.0013 | 0.0001 | 0.0001 | 0.0015 | 0.0001 | 0.0001 | 0.0014 | 0.0001 | 0 |
| Bud Site | 0.0054 | 0.0004 | 0.0023 | 0.0004 | 0.0005 | 0.0001 | 0.0019 | 0.0005 | 0.0003 | 0.0026 | 0.0003 | 0 | 0.0075 | 0.0003 | 0.0007 | 0.0034 | 0.0002 | 0 |
| Cell Periphery | 0.0006 | 0.0002 | 0.0004 | 0.0002 | 0.0002 | 0.0002 | 0.0004 | 0.0002 | 0.0002 | 0.0003 | 0.0001 | 0.0002 | 0.0006 | 0.0001 | 0.0001 | 0.0004 | 0 | 0.0001 |
| Cytoplasm | 0.8236 | 0.9542 | 0.8907 | 0.8128 | 0.8098 | 0.892 | 0.7937 | 0.9568 | 0.9091 | 0.7762 | 0.8757 | 0.9132 | 0.7419 | 0.9571 | 0.8792 | 0.7851 | 0.8635 | 0.9484 |
| Cytoplasmic Foci | 0.0234 | 0.0079 | 0.0131 | 0.0215 | 0.0157 | 0.0123 | 0.017 | 0.0058 | 0.0105 | 0.0236 | 0.0216 | 0.0103 | 0.0328 | 0.0054 | 0.0135 | 0.0315 | 0.0133 | 0.0088 |
| Eisosomes | 0.0005 | 0 | 0 | 0 | 0.0001 | 0 | 0.0001 | 0 | 0 | 0.0001 | 0 | 0 | 0.0002 | 0 | 0 | 0.0002 | 0 | 0 |
| Endoplasmic Reticulum | 0.0293 | 0.0106 | 0.0214 | 0.0074 | 0.0159 | 0.0274 | 0.0412 | 0.0138 | 0.0087 | 0.0144 | 0.0071 | 0.0357 | 0.0192 | 0.0104 | 0.0115 | 0.0122 | 0.0101 | 0.0116 |
| Endosome | 0.0432 | 0.0192 | 0.0365 | 0.116 | 0.0752 | 0.0337 | 0.0519 | 0.0125 | 0.0322 | 0.0797 | 0.0634 | 0.0256 | 0.0648 | 0.0126 | 0.0431 | 0.0531 | 0.0786 | 0.0219 |
| Golgi | 0.0086 | 0.0015 | 0.004 | 0.0061 | 0.0073 | 0.0057 | 0.017 | 0.0021 | 0.0021 | 0.0121 | 0.0066 | 0.0041 | 0.0254 | 0.0022 | 0.013 | 0.0294 | 0.0173 | 0.0019 |
| Lipid Particles | 0.0052 | 0 | 0.0009 | 0.0001 | 0.0007 | 0.0006 | 0.0056 | 0.0001 | 0.0029 | 0.0016 | 0.0058 | 0.0001 | 0.0149 | 0.0004 | 0.0017 | 0.0025 | 0.0025 | 0 |
| Mitochondria | 0.0056 | 0.0004 | 0.0019 | 0.0011 | 0.0048 | 0.0075 | 0.0135 | 0.0005 | 0.0078 | 0.0184 | 0.0045 | 0.0015 | 0.0136 | 0.0025 | 0.0132 | 0.0276 | 0.0015 | 0.0012 |
| None | 0.0046 | 0.0005 | 0.0013 | 0.0026 | 0.0006 | 0.0031 | 0.0036 | 0.0005 | 0.001 | 0.0017 | 0.0008 | 0.0005 | 0.0029 | 0.0022 | 0.001 | 0.0006 | 0.0003 | 0.0003 |
| Nuclear Periphery | 0.0027 | 0.0004 | 0.0036 | 0.0043 | 0.0017 | 0.0067 | 0.0072 | 0.0008 | 0.0021 | 0.0075 | 0.0017 | 0.0017 | 0.0115 | 0.001 | 0.0033 | 0.0015 | 0.0025 | 0.0005 |
| Nucleolus | 0.0002 | 0 | 0.0001 | 0.0001 | 0 | 0 | 0.0002 | 0 | 0 | 0.0001 | 0.0001 | 0 | 0.0003 | 0 | 0 | 0.0001 | 0 | 0 |
| Nucleus | 0.0015 | 0.0005 | 0.0015 | 0.0067 | 0.0013 | 0.001 | 0.0041 | 0.0009 | 0.001 | 0.0034 | 0.0012 | 0.001 | 0.0072 | 0.001 | 0.0012 | 0.001 | 0.0009 | 0.0007 |
| Peroxisomes | 0.0045 | 0 | 0.0002 | 0.0001 | 0.0028 | 0.0002 | 0.0026 | 0 | 0.0043 | 0.0028 | 0.0036 | 0 | 0.0073 | 0.0001 | 0.0009 | 0.0061 | 0.0003 | 0 |
| Punctate Nuclear | 0.0028 | 0 | 0.0006 | 0.0009 | 0.0001 | 0.0003 | 0.004 | 0.0001 | 0.0006 | 0.0005 | 0.0008 | 0.0001 | 0.0022 | 0.0004 | 0.0011 | 0.0003 | 0.0003 | 0 |
| Vacuole | 0.0069 | 0.0028 | 0.0077 | 0.0138 | 0.0207 | 0.0029 | 0.0093 | 0.0039 | 0.01 | 0.0242 | 0.0033 | 0.0028 | 0.0088 | 0.0024 | 0.0067 | 0.0148 | 0.0045 | 0.0022 |
| Vacuole Periphery | 0.0017 | 0.0007 | 0.0018 | 0.004 | 0.0032 | 0.0017 | 0.0025 | 0.0006 | 0.0025 | 0.0077 | 0.0017 | 0.001 | 0.003 | 0.0005 | 0.0018 | 0.0046 | 0.0026 | 0.0009 |
Sequencing Data
| R1 | R2 | |||||||||
|---|---|---|---|---|---|---|---|---|---|---|
| G1 Post-START | S/G2 | Metaphase | Anaphase | Telophase | G1 Post-START | S/G2 | Metaphase | Anaphase | Telophase | |
| Gene Expression | 92.4268 | 63.8845 | 77.1122 | 64.8462 | 69.1833 | 68.5675 | 55.3351 | 65.9757 | 58.7128 | 58.8145 |
| Translational Efficiency | 1.1734 | 1.5563 | 1.1825 | 1.4838 | 1.2994 | 1.2842 | 1.3892 | 1.102 | 1.2282 | 1.2417 |
Hit Data
| Dataset | Hit |
|---|---|
| Protein Concentration | ✘ |
| Protein Localization | ✘ |
| Gene Expression | ✘ |
| Translational Efficiency | ✘ |
Endocytosis
| Temp | Actin Patch (Sac6-tdTomato) | Cortical Patch (Sla1-GFP) | Late Endosome (Snf7-GFP) | Vacuole (Vph1-GFP) |
|---|---|---|---|---|
| 37℃ | ||||
| RT |
Cell Cycle Omics
CYCLoPs (Npa3-GFP)
| Gene / Allele | Actin Patch (Sac6-tdTomato) | Cortical Patch (Sla1-GFP) | Late Endosome (Snf7-GFP) | Vacuole (Sac6-tdTomato) |
|---|
| Gene | Images |
|---|
| Gene | Images |
|---|
Images are not yet available
Images are not yet available